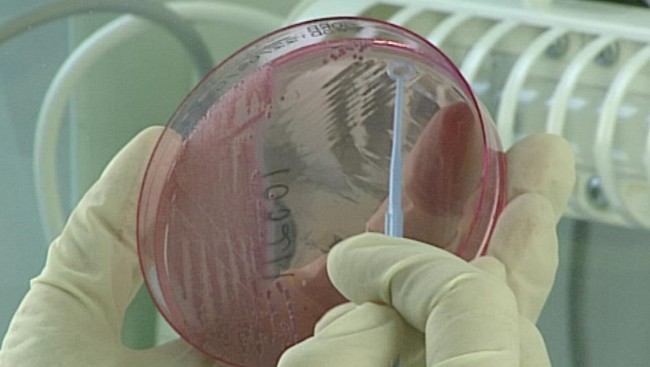
Najnowsze wyniki badań E-coli

Strona korzysta z plików cookie
Nasza strona korzysta z plików cookie w celu optymalizacji działania strony, analizowania ruchu oraz dostosowywania treści i reklam do Twoich preferencji. Zgodnie z wymogami Google, korzystamy z trybu zgody, który pozwala kontrolować, jakie dane są gromadzone i przetwarzane. Możesz wyrazić zgodę na wszystkie kategorie plików cookie lub zarządzać swoimi preferencjami. Więcej informacji znajdziesz w naszej Polityce prywatności.

31-03-2009 12:41
2
0
Zgłoś